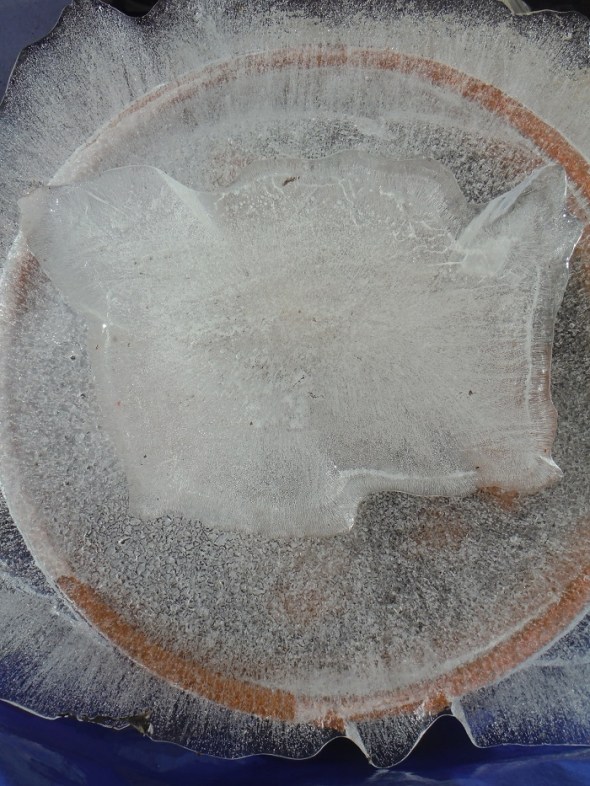
Ice flower 5_Toronto_January 2016

Melissanthi (Μελισσάνθη) : “Resarcimiento” / “Atonement”
Posted: January 6, 2016 Filed under: English, Melissanthi, Spanish | Tags: Greek women poets, Poetisas griegas Comments Off on Melissanthi (Μελισσάνθη) : “Resarcimiento” / “Atonement”Melissanthi (nombre real: Eva Chougia, Athens, ~1907-1991)
Resarcimiento
.
Cada vez que pequé pues una puerta abrió a medias
y los ángeles que no me habían considerado bella en mi castidad
inclinaron las vasijas de sus almas florecientes.
Cada vez que pequé una puerta pareció estar abierta
y lágrimas de compasión gotearon en la hierba.
Pero cuando la espada de mi arrepentimiento me empujó de los cielos,
cada vez que pequé una puerta se puso medioabierta:
la gente me consideró fea;
los ángeles pensaron que yo fue bella.
. . .
Melissanthi (born Eva Chougia, Athens, ~1907-1991)
Atonement
.
Each time I sinned a door half-opened
and the angels who hadn’t thought me beautiful in my chastity
tipped the vessels of their flowering souls.
Each time I sinned a door seemed to open
and tears of compassion dripped in the grass.
But if the sword of my remorse pushed me from the skies
each time I sinned a door half-opened.:
the people thought me ugly;
only the angels thought me beautiful.
. . .
Translation from the Greek / Traducción del griego: Karen Emmerich
. . .
Born Eva Chougia, the poet wrote under the pen-name of Melissanthi. She learned French, German and English, translating the works of poets such as Emily Dickinson, Robert Frost and Rainer Maria Rilke. Melissanthi taught French in Athenian highschools and also wrote critical essays for newspapers and journals.
. . .
Melissanthi fue el pseudónimo de Eva Chougia, nativa de Atenas. Enseñó el francés en los preparatorios de la ciudad y escribió ensayos literários, publicados en revistas y periódicos. Tradujo también poemas por Emily Dickinson, Robert Frost y Rainer María Rilke.
. . . . .